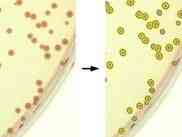
Thumbnail 3

What is OpenCFU?
The OpenCFU application provides a versatile and efficient tool for enumerating clustered circular objects, such as bacterial colonies, in digital images and live video streams. This cross-platform software enables users to quickly and reliably analyze their data, leveraging intuitive filtering capabilities to refine their analyses. Designed with a lightweight and open-source architecture, OpenCFU offers a robust and accessible solution for researchers and analysts working with this type of visual data
Highlights
- Cross-platform compatibility, allowing users on various operating systems to benefit from the application
- Ability to handle both digital images and live video feeds, providing flexibility in data sources
- Intuitive filtering tools that empower users to refine their analyses and extract meaningful insights from the data
- Fast and reliable performance, ensuring efficient processing of large or complex datasets
Features
Portable